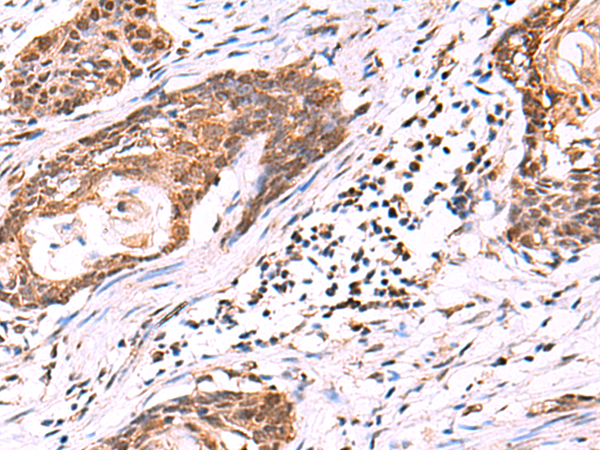

儲(chǔ) 存: 冷凍(-20℃)
|
Background: |
Regulates microtubule dynamics in Sertoli cells, a process that is essential for spermiogenesis and male fertility. Severs microtubules in an ATP-dependent manner, promoting rapid reorganization of cellular microtubule arrays (By similarity). Has microtubule-severing activity in vitro (PubMed:26929214). |
|
Applications: |
ELISA, WB, IHC |
|
Name of antibody: |
KATNAL1 |
|
Immunogen: |
Fusion protein of human KATNAL1 |
|
Full name: |
katanin catalytic subunit A1 like 1 |
|
SwissProt: |
Q9BW62 |
|
ELISA Recommended dilution: |
5000-10000 |
|
IHC positive control: |
Human cervical cancer and Human esophagus cancer |
|
IHC Recommend dilution: |
50-300 |
|
WB Predicted band size: |
55 kDa |
|
WB Positive control: |
Mouse brain tissue lysate |
|
WB Recommended dilution: |
500-2000 |

購物車
購物車 幫助
幫助
 021-54845833/15800441009
021-54845833/15800441009
